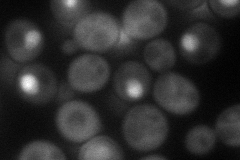
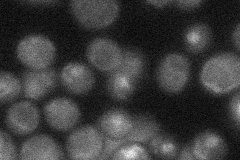

View description
Repressor of G1 transcription that binds to SCB binding factor (SBF) at SCB target promoters in early G1; phosphorylation of Whi5p by the CDK, Cln3p/Cdc28p relieves repression and promoter binding by Whi5; periodically expressed in G1
Localization:
Intensity:
Fold change:
Significance:
-
C’ GFP library in SD

nucleus29.82 -
N' NOP1pr-GFP in SD
cytosol,nucleus67.0201 -
N' TEF2pr-mCherry in SD

nucleus65.8784 -
N' NATIVEpr-GFP in SD
nucleus22.4608 -
N' TEF2pr-VC and Cyto-VN in SD

cytosol,nucleus43.5632 -
C’ GFP library in SD+DTT

nucleus31.051.04No -
C’ GFP library in SD+H2O2

nucleus31.981.07No -
C’ GFP library in Starvation Media

nucleus30.131.01No -
C’ GFP library on the background of Pup2-DaMP

nucleus -
C’ GFP library on the background of CCT mutant

nucleus34.79841.16658No
